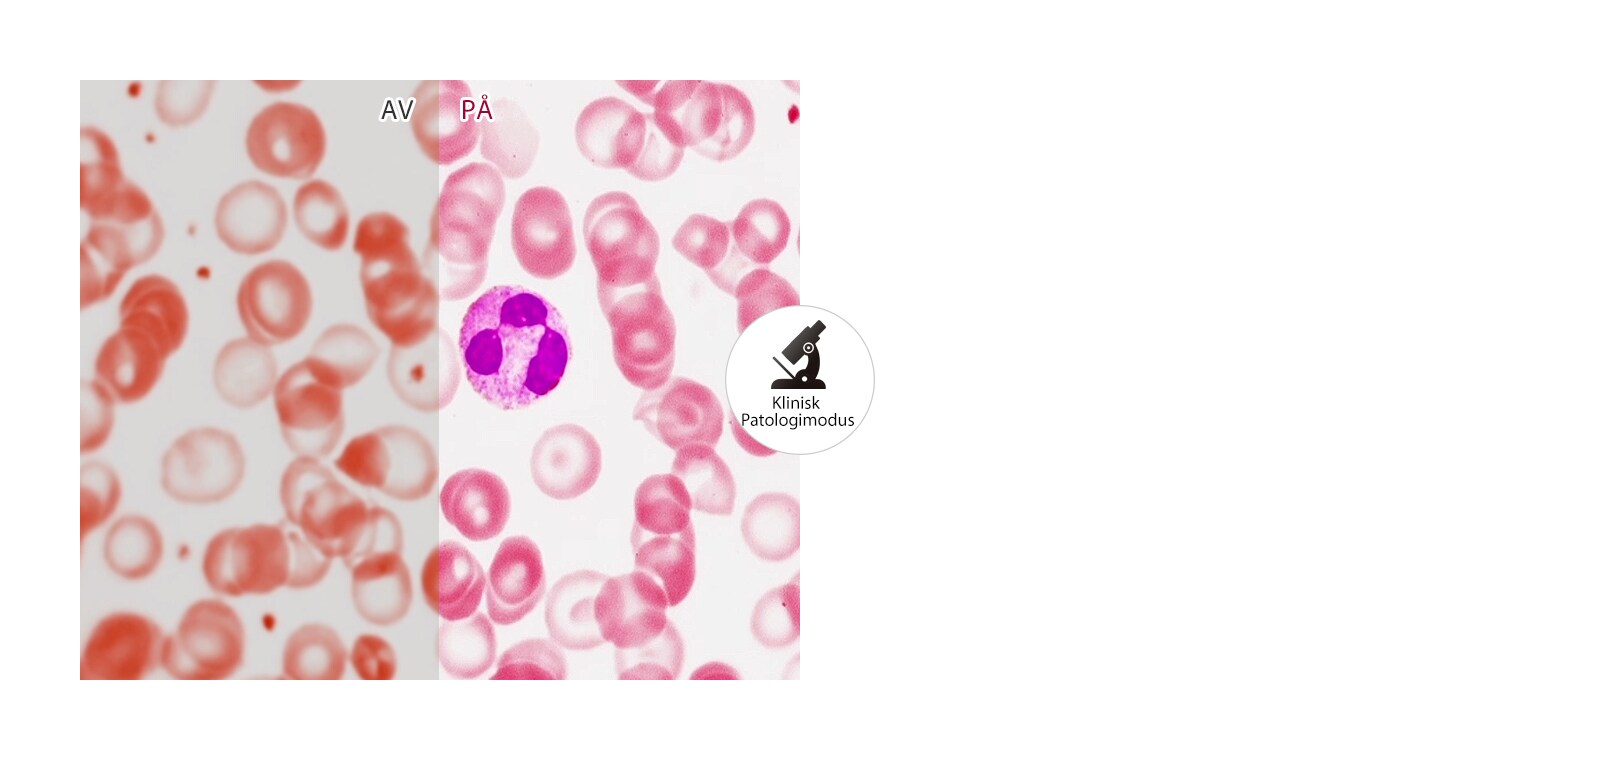
Realistisk fargegjengivelse1

LEGG TIL I ØNSKELISTE
Legg til artikler i MYLG-ønskelisten
Se ønskeliste
Utgått
32HL512D-B
Kopier modellnavn
31,5'' LG 8 MP Diagnostisk monitor
component-OBScountrySelectDesc
*titleText*
Modellnavnet er kopiert
Se forhandler for prisinformasjon
Begrenset antall salg
Tilgjengelig mengde
*quantity* stk
-
Produktpris(32HL512D-B)
$*rPrice*$*rPromoPrice**discountPDPMsg*Pris for LG-medlemmer(32HL512D-B)$*rMemberPrice*$*rMembershipPrice**discountPDPMsg*vip-price-message(32HL512D-B)$*rPrice*$*rVipPrice**discountPDPMsg*OBS_CHEAPERPRICE_MSG $*cheaperPrice*
Pris for LG-medlemmer$*rMembershipPrice**rWelcomePriceDescription**rWelcomePriceTooltip*
$*rWelcomePrice*
Totalt
MSRP
$*improveTotalPrice*
MSRP
$
Se forhandler for prisinformasjon
OBS_MEMBERSHIP_MSG $*recommendedMembershipPrice*
┗ *modelName*
$*discountedPrice*
*userFriendlyName*
bundle-unable-text
$*discountedPrice*
Save $*discountPrice*
component-protectYour
0 component-selectedItems
*modelName*
$*rPrice*.*rPriceCent*
$*rPromoPrice*.*rPromoPriceCent*
*discountMsg*
OBS_LOWEST_PRICE_MARK_MSG
*retailerPricingText*
*modelName*
$*rPrice*.*rPriceCent*
$*rPromoPrice*.*rPromoPriceCent*
*discountMsg*
OBS_LOWEST_PRICE_MARK_MSG
*retailerPricingText*
31,5" LG 8 MP Diagnostisk monitor
SKJERM
-
- Sideforhold
- 16:9
- Lysstyrke (Typ.)
- 450
-
- Lysstyrke (DICOM-kal.)
- 250/350
- Fargeområde (Typ.)
- DCI-P3 98% (CIE1976)
-
- Kontrastforhold (Typ.)
- 1300:1
- Paneltype
- IPS
-
- Topplysstyrke (Typ.)
- 450
- Pikselavstand
- 0,18159(H) x 0,18159(V) mm
-
- Oppløsning
- 3840 x 2160
- Responstid (GTG)
- 14 ms (Av), 5 ms(Raskere)
-
- Størrelse (tommer)
- 31,5
- Størrelse (cm)
- 80,0051
-
- Overflatebehandling
- Antirefleks
- Visningsvinkel (CR≥10)
- 178(H/V), 178(O/N)
FUNKSJON
-
- Automatisk luminans-sensor
- Ja
- Sort-stabilisator
- Ja
-
- Fabrikk-kalibrering
- Ja (Delta E<5, Gamma 1,8~2,6/DICOM-kurve)
- DICOM
- Ja (<=10 %)
-
- Fargetemperatur
- 6500 K / 8500 K / 9300 K Brukerhåndbok (5000 K ~ 10000 K)
- Sikker mot flimring
- Ja
-
- HDR10
- Ja
- HDR-effekt
- Ja
-
- HW-kalibrering
- JA (PerfektLum)
- OSD-språk
- 17 språk
-
- PBP
- JA (2PBP)
- Patologi
- JA
-
- Bildemodus
- (SDR )Tilpasset, Mono, Patologi, Leser, Klar, HDR-effekt, DICOM (klinisk), DICOM (diagnostisk), Kalibrering 1, Kalibrering 2, (HDR ) Tilpasset, Klar, Standard
- Lesemodus
- JA
-
- Smart energisparing
- JA
- Super Resolution+
- Ja
-
- Uniformitet
- Ja
PROGRAMVARE
-
- Dobbel-kontroller
- JA
- OnScreen Control (LG skjermadministrator)
- JA
-
- Qubyx
- JA
TILKOBLINGSEGENSKAPER
-
- DP Versjon
- 1,4
- DisplayPort
- JA (2 hver)
-
- HDMI
- JA (1 hver)
- HDMI-versjon
- 2.0
-
- USB utgangsport
- JA (2 hver/ver2.0)
- USB inngangsport
- JA (1 hver/ver2.0)
EFFEKT
-
- AC-inngang
- 100-240 Vac, 50/60 Hz
- DC-effekt
- 19 V, 3,42 A
-
- Strømforbruk (DC av)
- Lavere enn 0,3 W
- Strømforbruk (maks.)
- 65W
-
- Strømforbruk (Dvalemodus)
- Mindre enn 1,2W
- Type
- Ekstern strøm (Adapter)
MEKANISK
-
- Posisjonsjusteringer for display
- Vipp/høyde/dreiing
- Nedhøyde
- 85,3
-
- Høydeområde
- 0~110 mm
- Sving
- Toveis
-
- Vipp
- JA
- Kan monteres på vegg
- 100 x 100 mm
Dimensjoner/vekt
-
- Størrelse ved frakt (B x H x D)
- 822 X 537 X 215 mm
- Dimensjoner med stativ (B x H x D)
- 718,2 X 598,0 X 231,2 mm (Opp), 718,2 X 488,0 X 231,2 mm (Ned)
-
- Dimensjoner uten stativ (B x H x D)
- 718,2 x 414,3 x 45,1 mm
- Pallefyll (20ft/40ft/40ft HC)
- Skal defineres
-
- Vekt ved frakt
- Skal defineres
- Vekt med stativ
- 7,3 kg
-
- Vekt uten stativ
- 5,9 kg
STANDARD
-
- IEC (IEC 60601-1 / IEC 60601-1-2)
- Ja
- EN (EN 60601-1 / EN 60601-1-2)
- Ja
-
- cUL (ANSI/AAMI ES 60601-1, CSA CAN/CSA-C22.2 NO. 60601-1)
- Ja
- FCC (FCC del 15 Klasse A)
- Ja
-
- FDA
- 510(k) (Klasse II)
- CE (MDD 93/42/EEC, 2007/47/EC)
- Ja
-
- ISO13485
- Ja
- GMP
- Ja
-
- KGMP
- Ja
- RoHS
- Ja
-
- REACH
- Ja
- WEEE
- Ja
-
- MFDS
- Ja
TILBEHØR
-
- Adapter
- Ja
- Kalibreringsrapport (papir)
-
JA
-
- Displayport
- JA
- HDMI
- JA
-
- Strømledning
-
JA
Ettergivenhetsinformasjon
- The safety information for accessories is included with the safety information for the product and is not provided separately.
- Sikkerhetsinformasjonen for tilbehør følger med sikkerhetsinformasjonen for produktet og leveres ikke separat.
- For å lære mer om hvordan dette produktet håndterer data og dine rettigheter som bruker, besøk «Datadekning og spesifikasjoner» på LG Privacy.
Hva folk sier
SPØRSMÅL? VI KAN HJELPE DEG
Vis 32HL512D-B Produktstøtte
-
Register et Produkt Finn den nyeste produktinformasjonen og nyttige tips ved å registrere produktet Les mer
-
Brukermanualer Finn og last ned informasjon om ditt LG-produkt Les mer
-
Programvare og oppdateringer Ha ditt LG-produkt uppdatert med den seneste programvaren Les mer
-
Reservedeler og tilbehør Kjøp LG reservedeler og tilbehør Les mer
-
Garanti Les mer om våre garantier Les mer
-
Last opp et dokument Last opp et dokument for service og support Les mer
-
Bestill en reperasjon Har du et produkt som trenger service? Les mer
Velg kundestøtteløsning fra ikonene nedenfor:
-
VIA CHAT
-
MED TELEFON Ring våres Kundestøtte: 23 25 25 63
Mandag til fredag: 08:00 til 17:00
Helligdager: Stengt -
MED E-POST Send en henvendelse til LG sin tekniske kundestøtte
$*rPrice*.*rPriceCent*
$*rPromoPrice*.*rPromoPriceCent*
*discountMsg*
*retailerPricingText*
OBS_MEMBERSHIP_MSG $*siblingMembershipPrice*
*obsMemberShipLinkEnd*